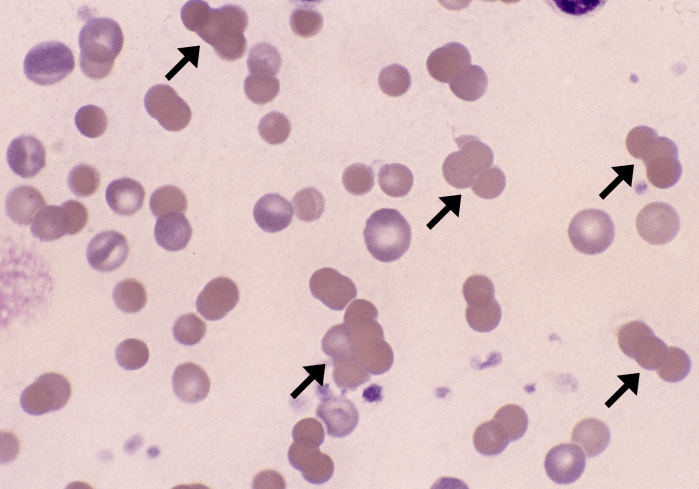
Agglutination 1 (Canine 1) ARROWS

Agglutination
Morphology: three-dimensional clumps of red blood cells. Caused by antibodies binding red blood cells together.
Look alike: rouleaux. Agglutination can be distinguished from rouleaux with a saline dilution test: place one drop of blood on a slide, add 4 – 10 drops of 0.9% NaCl, examine the slide as a wet mount with a coverslip. Saline dilution will disperse rouleaux but not agglutination.
Clinical relevance: usually indicates immune-mediated hemolytic anemia (IMHA).

